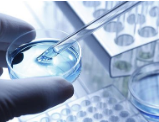

我们提出了十大值得关注的医疗发展趋势。
行业预测 健康服务 医药

国家中医药管理局办公室关于印发二级公立中医医院绩效考核指标的通知
公立中医医院 二级医院 绩效考核

国家卫健委统计信息中心发布3月全国医疗服务情况及3月底全国医疗卫生机构数。
医疗服务 3月 医疗卫生机构数

国家卫健委统计信息中心公布1-3月全国医疗服务及二级以上公立医院病人费用情况。
公立医院 医疗服务 病人费用

医疗的互联网化对原有监管模式提出了新的挑战。
互联网诊疗 新业态 两会

由于此次疫情防控工作的突发性,在个人信息利用过程中存在信息管理制度不细致、技术手段不到位等问题,导致信息泄露、丢失、滥用...
个人信息保护 疫情防控 信息安全

据韩联社报道,韩国中央防疫对策本部26日通报称,截至当天零时,韩国出现2例被称为“儿童怪病”的小儿多系统发炎症候群疑似病...
“儿童怪病” 韩国 新冠肺炎

当前,我国疫情进入常态化防控新阶段。如何在抓好常态化防控的同时,及时总结、分析、反思前一阶段的工作,为未来公立医院的改革...
焦雅辉 疫情防控 医院管理

由上海探偲商务信息咨询有限公司(Taas Labs)主办的T-Bio亚洲生物医药产业创新峰会将于2020年9月3日-4日...
生物医药 亚洲生物医药产业创新峰会 合作会议

习近平强调,人民军队听党指挥、闻令而动,在疫情防控斗争中发挥了重要作用、作出了突出贡献。
医学科研 疫苗研发 习近平
安徽省新认定3家省重点实验室,分别是:依托中国科学技术大学附属第一医院(安徽省立医院)组建的造血干细胞及移植安徽省重点实...
重点实验室 生命健康 安徽省

6月30日0—24时,疫情最新情况。

第49期·医健科技圈点 | 公立医疗机构“互联网+医疗服务”项目技术规范与财务管理新规出台
公立医疗机构 圈点 医健科技

第50期·医健科技圈点 | 2020年政府工作报告:总结抗疫工作,提出医疗卫生重点任务
政府工作报告 抗疫 医健科技

笔者仅从法律的角度就手术网络直播合规性进行探讨,并结合医疗行业实际,提出个人看法。
医学理性认识 手术网络直播 医疗行业
2026-02-06
2026-02-05
2026-02-05
2026-02-04
2026-02-04

